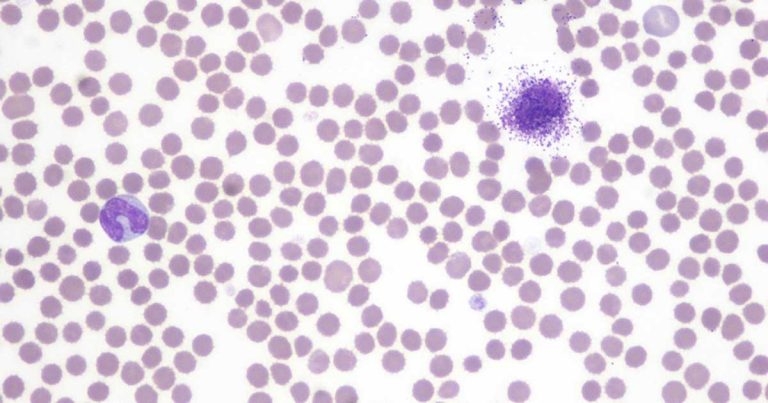

23 Feb 2021
Francesco Cian DVM, DipECVCP, FRCPath, MRCVS presents the case of Staffordshire bull terrier in the latest Diagnostic Dilemmas from Vet Times.
Figure 1. Circulating mast cells from the blood smear of a dog. Monolayer area (Figure 1).
The data (Table 1), the images and the graph are from an ethylenediamine tetra-acetic acid blood sample of an adult, male, Staffordshire bull terrier seen by the referring veterinarian for a few weeks’ history of progressive lameness.
One year before, the dog developed a mass on the R hindlimb that was surgically removed, but not submitted for histopathological examination. The mass has recently recurred and is accompanied by a more generalised leg swelling.

Note in the microphotographs (Figures 1 and 2) the presence of mononuclear cells with typical purple intracytoplasmic granules, often obscuring the nuclei. These cells are compatible with mast cells and account for 26% of all leukocytes present in the sample.
Towards the feathered edge of the smear, these cells are particularly numerous and form poorly cohesive groups. The automated haematology analyser was unable to identify these cells, hence the abnormal scattergram (Figure 3) and the lack of an automated leukocyte differential count.
A diagnosis of mastocytaemia was given.
A fine needle aspirate from the R hindlimb mass was performed and harvested large numbers of granulated mast cells similar to those observed in the peripheral blood. This was indicative of mast cell tumour (MCT) and was considered the likely cause for the reported mastocytaemia.
Mastocytaemia may be observed in patients with MCTs and, when present, suggests metastatic disease with dissemination of neoplastic mast cells within peripheral blood and/or bone marrow. However, mastocytaemia in dogs is not pathognomonic of MCT and may also be observed in other conditions.
Interestingly, severity of mastocytaemia without MCT may exceed that detected during tumour staging in dogs with MCT.
Automated haematology analysers are very precious tools that provide crucial information that helps in the diagnostic process. However, they are often unable to identify certain abnormalities (for example, atypical circulating cells, haemoparasites, various morphological changes affecting blood cell lines).
Therefore, blood smear examination should always accompany all automated blood counts and should be an integral part of any haemogram.
Finding circulating mast cells in blood smears from dogs may occur in patients with MCT, but it is not pathognomonic of it and may also be observed in association with other conditions. Knowing the clinical history of the animal may help to identify the most likely cause of it.